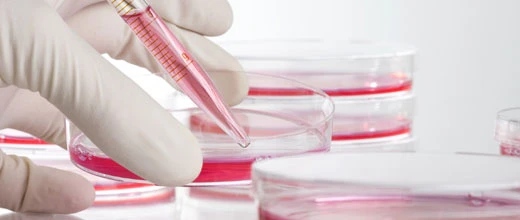
Vita 34: Stammzellbank gibt Gas

Das Biotech-Unternehmen Vita 34 hat sich auf die Einlagerung von Stammzellen spezialisiert. In der regenerativen Medizin finden diese Zellen immer häufiger Anwendung. Durch den großen Zuspruch profitiert Vita 34 – auch die Aktie liefert positive Signale.
Geschäftsmodell
Stammzellen werden bereits bei der Geburt aus der Nabelschnur gewonnen und über Jahrzehnte als Stamzelldepots tiefgefroren eingelagert. Vita 34 verwaltet derzeit 150.000 solcher Depots in Leipzig – Tendenz steigend. Durch die langfristigen Einlagerungen sind die Einnahmen gut kalkulierbar. Schon jetzt erzielt die Biotech-Firma hohe zweistellige Gewinnmargen. Doch Vita 34 will weiter wachsen.
Enormes Potenzial
Ein Blick auf den Chart zeigt: Die Aktie knackte vor kurzem den seit April 2015 bestehenden Abwärtstrend und stieg zudem über die 200-Tage-Linie. Fundamental sieht es ebenfalls gut aus: Die Papiere notieren deutlich unter Buchwert und warten mit einer attraktiven Dividendenrendite auf.

Mit dem Geschäftsmodell und der derzeitigen Marktpräsenz sollte Vita 34 weiter wachsen und die Papiere des Biotech-Konzerns ebenfalls profitieren. Welche Strategien CEO André Gerth verfolgt, lesen Sie im neuen AKTIONÄR (39/16), der seit Freitag im Handel ist.
Kann jeder Geld an der Börse verdienen?
Autor: Roth, Oliver
ISBN: 9783864703997
Seiten: 224
Erscheinungsdatum: 14.09.2016
Verlag: Börsenbuchverlag
Art: gebunden
Verfügbarkeit: als Taschenbuch erhältlich
Weitere Informationen und Bestellmöglichkeiten finden Sie hier
Als professioneller Börsenhändler beweist Oliver Roth seit Jahren, dass man »Börse können kann«. In seinem ersten Buch »Earning by Doing« gewährt er Einblicke in die Welt der Frankfurter Händler und zeigt, wie jeder Geld an der Börse verdienen kann.
Berufshändler beweisen durch ihre Existenz, dass die Börse nach bestimmten Regeln funktioniert, deren Kenntnis dauerhaft zu Gewinnen führt. Zahlreiche Anekdoten aus über 20 Jahren Börse, Geschichten vom Geschehen hinter den Kulissen und viele Tipps, Hinweise und Strategien für den eigenen Börsenerfolg ergeben ein einzigartiges Werk für Anleger. Jetzt auch als Taschenbuch!

 DER AKTIONÄR – Unsere App
DER AKTIONÄR – Unsere App

23.09.2016, 10:45
23.09.2016, 10:45


 Sofortkauf
Sofortkauf